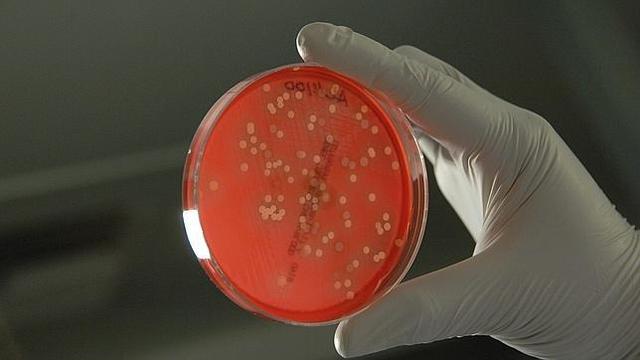
Primer cultivo de tejidos.

-
Conflicto bélico entre Gran Bretaña y los aliados afrikáners del Transvaal y el Estado Libre de Orange, comenzó en 1899 y se prolongó hasta 1902, en los territorios que actualmente forman Sudáfrica. Violencia: Estatal.
-
El inventor alemán Ferdinand von Zeppelin construye el dirigible rígido, un vehículo más ligero que el aire llamado zepelín en su honor.
-
La obra de Sigmund Freud, Interpretación de los sueños representa un avance en el campo del conocimiento de los mecanismos y motivaciones que rigen la conducta humana.
-
Es asesinado el presidente William McKinley en Buffalo durante una exposición, a tan solo 6 meses de haber iniciado su segundo mandato; lo sucede Teodore Roosevelt. Violencia Política.
-
En Macedonia ocupada por Turquía, se producen graves disputas entre búlgaros, griegos y serbios. Violencia Social.
-
En Sudamérica, Panamá se subleva contra Colombia y logra su independencia alentada por EE.UU. a quienes cede el istmo del canal. Violencia Estatal
-
En Asia, Japón comienza una guerra con Rusia, disputándose Corea. Violencia Estatal.
-
John Ambrose Fleming desarrolla el primer diodo de tubo de vacío, un dispositivo electrónico que convierte una corriente eléctrica alterna en una corriente continua.
-
La Guarda Imperial disparó contra una multitud de manifestantes frente al Palacio de Invierno de San Petersburgo. Violencia política.
-
El biólogo estadounidense Ross Granville Harrison descubre que los tejidos vivos pueden cultivarse, es decir, pueden crecer fuera de su órgano original.
-
Matthew Henson y los esquimales Ootah, Eguingwah, Ooqueah y Seegloo con 40 perros llegan al Polo Norte.
-
Movimiento armado de la Revolución. Se da inicio a la Revolución Mexicana. Violencia estatal.
-
Se demuestra la estructura interna del átomo, un pequeño núcleo alrededor del cual giran los electrones, la exploración científica del microcosmos de la materia comienza a recorrer un camino que se resultará insondable.
-
Participando Bulgaria, Serbia, Montenegro y Grecia contra Turquía . Constantinopla es amenazada y las potencias fuerzan una mediación. Creta y una parte de Macedonia son anexadas por Grecia. Violencia estatal.
-
En EE.UU. el empresario Henry Ford inventa la línea de montaje mecanizada para su planta de automóviles; la demanda está rebasado sus posibilidades de producción.
-
Serbia, el asesinato del heredero al trono de Austria, Francisco Fernando en Sarajevo marca el comienzo de la Primera Guerra Mundial, Austria le declara la guerra. Violencia estatal.
-
En Bombay, India, una multitud recibe a Mohamad Gandhi de regreso de Sudáfrica, líder de las reivindicaciones indias, donde ha residido sus últimos 25 años.
-
Albert Einstein propone su Teoría de la Relatividad General, las profundas impicancias de la misma no serán comprendidas acabadamente sino hasta décadas mas tarde.
-
En Rusia se produce la revolución bolchevique de marzo, abdica el zar Nicolás II y asume provisionalmente el gobierno como primer ministro el príncipe Georg E.Lvov a quien sucederá rápidamente Alexander Kerensky, paralelamente se firma un armisticio con Alemania. Lenin se convierte en el jefe indiscutido de los bolcheviques; un año antes ha ocurrido el asesinato del monje Rasputín influyente de la corte. Violencia Política.
-
Woodrow Wilson es reelegido presidente en los EE.UU. Éste mismo año se suma como beligerante al conflicto europeo declarándole la guerra a Alemania.
-
Durante este año, con la participación de EE.UU. en la guerra y la designación del mariscal Foch al frente de las tropas, finalmente capitulan Bulgaria, Turquía , Austria y por último Alemania; se produce la desintegración del imperio austro-húngaro y logran su independencia Finlandia , Polonia y Checoslovaquia, entre otros países y finalizando así la primera gran guerra.
-
En la India el ejército británico lleva a cabo una sangrienta represión en Amristar, el suceso consolidara aun mas la determinación hindú de conquistar su libertad. Pocos mas de dos décadas más tarde Inglaterra habrá de otorgarle su independencia y al mismo tiempo habrá perdido definitivamente su condición de imperio. Violencia estatal.
-
Finalizada la Primera Guerra Mundial y vigente el Tratado de Versalles, se producen importantes transformaciones políticas en Europa ; en el mes de junio se firma el tratado por el cual se obliga a Alemania al desarme militar casi total, al pago de gravosas reparaciones de guerra, la entrega de territorios a Polonia y la admisión de fuerzas de ocupación. El balance de víctimas al fin de la guerra asciende a 10 millones de muertos.
-
Inicio del movimiento no violento de Gandhi en defensa de los derechos humanos en La India.
-
Adolf Hitler asume la presidencia del Partido Nacional Socialista.
-
- Creación de la Unión Soviética mediante el Tratado de Creación de la URSS.
-
Pancho Villa fue emboscado y asesinado la tarde del 20 de julio de 1923, cuando se dirigía a una fiesta familiar en Parral, Chihuahua.
Su cadáver fue decapitado. En esta profanación intervinieron ayudantes locales y el estadounidense Handal, pagado por el rey de la prensa estadounidense.
William Randolph Hearst, quien desembolsó cinco mil dólares por la cabeza de Villa, trocada en dantesco trofeo. -
La ocupación estadounidense de Haiti comenzó el 28 de julio de 1915, cuando 330 Marines desembarcaron en Port-au-Prince bajo la autoridad del entonces presidente de los Estados Unidos Woodrow.
-
Las SS se establecieron en 1925 como guardia personal del líder nazi Adolf Hitler. Bajo el mandato de Heinrich Himmler, las SS pasaron de ser una pequeña formación paramilitar a convertirse en una de las más grandes y poderosas organizaciones dentro del Tercer Reich.
-
Se denomina hormigón pretensado (en algunos lugares de Hispanoamérica concreto preesforzado) a la tecnología de construcción de elementos estructurales de hormigón sometidos intencionadamente a esfuerzos de compresión previos a su puesta en servicio. Dichos esfuerzos se consiguen mediante barras, alambres o cables de alambres de acero que son tensados y anclados al hormigón.
-
Charles Augustus Lindbergh (Detroit, 4 de febrero de 1902 – Maui, 26 de agosto de 1974) fue un aviador e ingeniero estadounidense.
En 1927 alcanzó la condición de primer piloto en cruzar el océano Atlántico, de oeste a este, uniendo el continente americano y el continente europeo en un vuelo sin escalas en solitario. -
La masacre de las bananeras es un episodio ocurrido en la población colombiana en ciénaga en 1928 cuando las fuerzas armadas de Colombia abrieron fuego contra un número indeterminado de manifestantes. Tal vez no exista en la historia del país un hecho tan doloroso y al mismo tiempo tan sometido a los vaivenes de la ficción como lo ocurrido en la noche entre el 5 y 6 de diciembre de 1928 en Ciénaga, Magdalena.
-
Fue una masacre supuestamente ordenada por Al Capone contra cinco miembros de la banda de “North Side Gang” (Pandilla lado norte) más el doctor Reinhardt H. Schwimmer en Chicago el día de San Valentín
-
El Golpe de Estado de Argentina de 1930 se refiere a el cual un grupo de militares encabezado por el general José Félix Uriburu se apoderó del gobierno, derrocando al presidente Hipólito Yrigoyen y estableciendo una dictadura militar.
No fue el primer intento de golpe de estado posterior a la sanción de la Constitución en 1853, pero sí el primero en tener éxito total. -
Se produjo un incidente en el que se vio envuelto el ejército japonés que custodiaba el ferrocarril del Sur de Manchuria, de propiedad nipona. Japón acusó a los chinos (divididos en facciones independientes del poder central de Pekín) de volar parte del tramo de dicho ferrocarril.
Muchos pensaron que en realidad los responsables del sabotaje habían sido miembros del propio ejército japonés, y que el acto era una mera excusa para anexionarse el territorio chino. -
Fue la guerra más importante en Sudamérica durante el siglo XX. En los 3 años de duración, Bolivia movilizó 250 000 soldados y Paraguay 120 000, que se enfrentaron en combates en los que hubo gran cantidad de bajas (60 000 bolivianos y 30 000 paraguayos), y gran cantidad de heridos, mutilados y desaparecidos.
-
El Partido Nazi se convierte cada vez más radical en sus opiniones sobre el tratamiento de las minorías en Alemania, sobre todo hacia judíos. La base del pensamiento nazi fue la idea de una sociedad dividida en categorías, la Volksgemeinschaft (la comunidad popular), que supondría ser la espina dorsal de la sociedad de la futura Alemania.
-
Fue un campo de concentración nazi cercano al pueblo de Dachau, a 13 km al noroeste de Múnich, en Baviera (sur de Alemania).
El campo fue construido sobre una fábrica de pólvora en desuso y sus instalaciones principales fueron terminadas el 21 de marzo de 1933. Al día siguiente, los primeros prisioneros fueron internados en el campo. -
Tras convencer a Hitler de la conveniencia de intentar un golpe de Estado, asegurándole que contaban con el apoyo del Ejército, los conspiradores, encabezados por el dirigente del NSDAP austriaco Theodor Habicht, planearon secuestrar al presidente Miklas y al gabinete y, tras capturar la radio, anunciar la proclamación de un nuevo Gobierno encabezado por el embajador austriaco en Italia, Anton Rintelen.
-
Cien mil soldados del Ejército italiano comandados por el mariscal Emilio De Bono atacaron desde Eritrea (en ese entonces posesión colonial italiana) sin declaración previa de guerra. Al mismo tiempo una fuerza menor comandada por el general Rodolfo Graziani atacó desde la Somalia Italiana
La población etíope sufrió mucho con la conquista. Se calcula que la población paso de 16 millones a solo 5 o 9 millones. -
La guerra tuvo múltiples facetas, pues incluyó lucha de clases, guerra de religión, enfrentamiento de nacionalismos opuestos, lucha entre dictadura militar y democracia republicana, entre revolución y contrarrevolución, entre fascismo y comunismo.
-
China luchó contra Japón con apoyo económico de Alemania, la Unión Soviética y los Estados Unidos. Después del ataque japonés a Pearl Harbor.
-
Adolf Hitler reclama la anexión de Checoslovaquia. Su pretexto fueron la supuestas necesidades sufridas por las poblaciones germanas que habitaban las regiones fronterizas con Checoslovaquia en el norte y oeste, conocidas colectivamente como los Sudetes. La incorporación de los territorios limítrofes Checoslovacos a la Alemania nazi, dejaría al resto del país incapaz de resistir a la posterior ocupación.
-
La invasión alemana de Polonia, el primer paso bélico de la Alemania nazi en su pretensión de fundar un gran imperio en Europa que produjo la inmediata declaración de guerra de Francia y la mayor parte de los países del Imperio británico y la Commonwealth al Tercer Reich.
-
En Inglaterra, Churchill aprueba la fabricación de armas atómicas, sus avances son compartidos con EE.UU.
-
Japón ataca sorpresivamente con una fuerza aeronaval la base naval de Pearl Harbour en el Pacífico provocando el ingreso de EE.UU
-
En Europa oriental se desarrolla la batalla de Stalingrado entre rusos y alemanes.
-
Los aliados iniciaron el desembarco de un ejército más de 150.000 soldados (73.000 norteamericanos y 83.000 británicos y canadienses) sobre las playas de Normandía.
-
-
Estados Unidos utiliza el arma nuclear Little Boy sobre Hiroshima.
-
Estados Unidos bombardea Nagasaki con la bomba atómica denominada Fat Man.
-
El Plan Marshall es aprobado por el Senado de los Estados Unidos. Fue el principal plan de los Estados Unidos para la reconstrucción de los países europeos después de la Segunda Guerra Mundial, que a la vez estaba destinado a contener un posible avance del comunismo.
-
Estalla la guerra con los países árabes.
-
En Europa diez naciones europeas conjuntamente con EE.UU. y Canadá forman el Pacto del Atlántico Norte (OTAN) conocido como NATO.
-
En Asia estalla la guerra de Corea. Corea del Sur apoyada por los EE.UU. y sus aliados se enfrenta a Corea del Norte apoyada por el bloque comunista.
-
En Jordania es asesinado el rey Abdullah, lo sucede Tala I pero es reemplazado por el parlamento quien designa como sucesor a su hijo Hussein.
-
Detonación de la primera bomba de hidrógeno, basada en la fusión nuclear en las islas Marshall en el Pacífico.
-
Vietnam libera su territorio septentrional de manos francesas.
-
En Argentina es derrocado el gobierno del general Juan D. Perón por un alzamiento cívico-militar.
-
En Medio Oriente estalla la Guerra de Suez debido a las restricciones impuestas por Egipto a Israel para la navegación en el canal.
-
Rusia lanza el primer satélite artificial, el Sputnik I; el suceso, de fuertes implicancias estratégicas y militares impacta a los EE.UU.
-
En Irak es derrocada la monarquía del rey Faisal en forma cruenta y la familia real es ejecutada, por el general Abdul Karim Kassim quien instaura un régimen militar de ideología nacionalista iniciando una nueva política exterior orientada hacia la órbita soviética.
-
Guerra de Vietnam, enfrentamiento militar que tuvo lugar en Vietnam desde 1959 hasta 1975, cuyo origen fue la determinación de las guerrillas comunistas (el llamado Vietcong) de Vietnam del Sur, apoyadas por Vietnam del Norte, de derrocar al gobierno survietnamita.
-
Durante la segunda ola de feminismos se trataron una variedad de temas, como la desigualdad no-oficial (de facto), la sexualidad, la familia, el lugar de trabajo y los derechos en la reproducción. Al final de este movimiento se intentó añadir una enmienda de igualdad de derechos a la constitución de Estados Unidos
-
Es una guerra asimétrica de baja intensidad que se desarrolla en Colombia desde la década de 1960 hasta la actualidad.
-
Fue un sismo ocurrido el domingo 22 de mayo de 1960 a las 15:11 hora local.
Su epicentro se localizó en Lumaco, provincia de Malleco, y tuvo una magnitud de 9,5 MW,siendo así el más potente registrado en la historia de la humanidad. Junto con el evento principal se produjo una serie de movimientos telúricos de importancia que afectó a gran parte del sur de Chile.
El sismo fue percibido en distintos puntos del planeta y produjo un maremoto y así como la erupción del volcán Puyehue. -
Fue una operación militar en la que tropas de cubanos exiliados, apoyados por Estados Unidos invadieron Cuba, para intentar crear una cabeza de playa, formar un gobierno provisional y buscar el apoyo de la OEA y el reconocimiento de la comunidad internacional.
-
Fue un muro de seguridad que formó parte de la frontera Inter alemana que separó la zona de la ciudad berlinesa encuadrada en el espacio económico de la República Federal de Alemania (RFA), Berlín Oeste, de la capital de la RDA entre esos años. Es el símbolo más conocido de la Guerra fría y de la división de Alemania.
-
Conflicto entre los Estados Unidos, la Unión Soviética y Cuba generado a raíz del descubrimiento por parte de Estados Unidos de bases de misiles nucleares de alcance medio soviéticos en territorio cubano.
-
Nelson Mandela es llevado a prisión por 27 años.
-
El presidente Kennedy recibió varios impactos de bala en la calle Elm de Dallas, Texas mientras realizaba una visita política.
-
Se lleva a cabo la independencia de Sudán del gobierno egipcio, lo cual trae consigo millones de muertos y miles de migrantes.
-
Fue un conflicto bélico que enfrentó a Israel con una coalición árabe formada por la República Árabe Unida. La guerra de los Seis Días se inscribe dentro del conjunto de guerras libradas entre Israel y sus vecinos árabes, tras la creación del Estado de Israel en parte del Mandato británico de Palestina.
-
En el combate de Quebrada del Churo el Che Guevera es puesto prisionero y ejecutado por medio del gobierno de Bolivia.
-
Fue un movimiento social en el que además de estudiantes de la UNAM, IPN, UPN, la Universidad Iberoamericana, la Universidad La Salle y la Benemérita Universidad Autónoma de Puebla participaron profesores, intelectuales, amas de casa, obreros y profesionales en la Ciudad de México realizaron un movimiento que buscaba un cambio democrático en el país, mayores libertades políticas y civiles, menor desigualdad y la renuncia del gobierno del PRI que consideraban autoritario.
-
La misión espacial norteamericana Apolo 11 coloca a los primeros hombres en la Luna: el comandante Neil Armstrong y el piloto del módulo Edwin F.Aldrin.
-
Fue un movimiento muy prolífero en todo el mundo.
En un principio el movimiento se generó en Estado Unidos para luego extenderse a Europa y a todo el mundo. El origen, fue una reacción a las profundas alteraciones que había producido la segunda guerra mundial, en la sociedad y en la cultura.
Su estilo fue la psicodélica y la multiplicidad de colores inspirados en las drogas alucinógenas de la época (LSD) y que se plasmaba en: moda, artes gráficas y sobre todo en la música. -
El 4004 fue el primer microprocesador del mundo, creado en un simple chip y desarrollado por Intel.
-
La guerra empezó como una insurrección en Pakistán Oriental liderada por el movimiento Mukti Bahini (luchadores por la libertad). El apoyo indio a la insurgencia acabó en una guerra entre la India y Pakistán durante la cual el ejército de la India y los pakistaníes orientales derrotaron decisivamente a las fuerzas de Pakistán occidental desplazadas al oeste. La guerra acabó con la independencia de Pakistán Oriental como la nueva nación de Bangladés.
-
Dedicada al sector del software y el hardware, tiene su sede en Redmond, Washington. Microsoft desarrolla, fabrica, licencia y produce software y equipos electrónicos, siendo sus productos más usados el sistema operativo Microsoft Windows y la suite Microsoft Office, los cuales tienen una importante posición entre las computadoras personales
-
Fue una invasión marroquí al territorio del Sahara español. Se reunifica el territorio del Sahara al reino de Marruecos.
-
Durante varias negociaciones, los presidentes de Estados Unidos de América y la República de Panamá firman el tratado donde Estados Unidos devuelve a Panamá los derechos sobre el canal de Panamá.
-
El descontento popular, alcanza su punto álgido en 1978: se temía una revolución y el presidente de Estados Unidos, Jimmy Carter, pidió al shah que emprendiera reformas democratizadoras. Mohammad Reza puso entonces en pie varios gobiernos liberalizadores que cayeron uno tras otro. La revolución parecía inminente y, en efecto, el 16 de enero de 1979 el Shah debió exiliarse.
-
Fue la persona en ese cargo por mayor tiempo durante el siglo XX y la primera mujer que ocupó este puesto en su país. Su firmeza para dirigir los asuntos de Estado, su dominio sobre los ministros de su gabinete y su fuerte política monetarista le valieron el sobrenombre de la Dama de Hierro. Como jefa de gobierno, su llegada al poder supuso una completa transformación del Reino Unido al apoyar la privatización de empresas estatales, de la educación y de los medios de ayuda social.
-
Una huelga de más de 17 mil trabajadores en los astilleros de Gdansk forzó al gobierno comunista de Polonia a legalizar Solidarnosc, el primer sindicato independiente y pocos meses después, la organización contaba con más de 10 millones de miembros y jugaría un papel fundamental en las primeras elecciones polacas.
-
Irak había roto relaciones diplomáticas con Irán, debido a conflictos territoriales, puesto que Irak quería invertir la delimitación de fronteras entre los dos estados, establecida en los Acuerdos de Argel (1975), la creencia del presidente de Irak, Saddam Hussein era reconquistar Shatt al-Arab y la provincia iraní de Juzestán para Irak.
-
Denominada por Israel "Operación Paz para Galilea" y también a veces conocida como Primera Guerra del Líbano, fue un conflicto armado que dio inicio cuando las Fuerzas de Defensa de Israel invadieron el sur del Líbano con el objetivo de expulsar a la OLP de dicho país. El Gobierno de Israel ordenó la invasión como respuesta al intento de asesinato del embajador israelí en el Reino Unido, Shlomo Argov, por parte del grupo de Abu Nidal.
-
Fue una invasión a la nación insular de Granada por los Estados Unidos y varias otras naciones caribeñas en respuesta al golpe de Estado de Hudson Austin y su alianza militar cubano-soviética. El 25 de octubre de 1983 los Estados Unidos, Barbados, Jamaica y miembros de la Organización de Estados del Caribe Oriental desembarcaron buques en Granada, derrotaron a la resistencia granadina y cubana y derrocaron el gobierno de Austin.
-
Accidente nuclear sucedido en la central nuclear Vladímir Ilich Lenin, a 18 km de la ciudad de Chernóbil, Ucrania. Considerado, junto con el accidente nuclear de Fukushima I en Japón de 2011, como el más grave en la Escala Internacional de Accidentes Nucleares. Constituye uno de los mayores desastres medioambientales de la historia.
-
Un conflicto armado que ocurrió entre febrero de 1988 y mayo de 1994 en el pequeño enclave armenio de Nagorno Karabaj (o Alto Karabaj), en la región sureste del Cáucaso, una antigua provincia soviética poblada por una minoría azerí y una mayoría de armenios, rodeada completamente por la República de Azerbaiyán. El parlamento del enclave votó a favor de la unión con Armenia, lo cual fue ratificado en un plebiscito que contó con una aplastante mayoría de la población favorable a la independencia.
-
Alvaro González Santana, era el padre de la juez Martha Lucía González Rodríguez, quién adelantó las investigaciones por las masacres ocurridas a comienzos del año 1988 en Urabá y Córdoba y se atrevió a llamar a juicio a Pablo Escobar y a Gonzalo Rodríguez Gacha, ya que encontró méritos para llamar a juicio a los dos grandes jefes del cartel de Medellín y tan sólo eso bastó para que estos dos sicarios atentaran contra la vida de su padre.
-
Una serie de manifestaciones lideradas por estudiantes en la República Popular China que solicitaban más democracia y libertad de expresión, entre otras demandas. Finalmente el ejército chino recibió la orden de intervenir y aplastar la revuelta la noche del 3 al 4 de junio y se calcula que hubo miles de muertos.
-
La caída del "muro de la vergüenza" vino motivada por la apertura de fronteras entre Austria y Hungría, ya que cada vez más alemanes viajaban a Hungría para pedir asilo en las distintas embajadas de la República Federal Alemana. Este hecho, motivó enormes manifestaciones que llevaron a que, el 9 de noviembre de 1989 el gobierno de la RDA afirmara que el paso hacia el oeste estaba permitido.
-
Fue un conflicto bélico librado por una fuerza de coalición autorizada por las Naciones Unidas, compuesta por 34 países y liderada por Estados Unidos, contra la República de Irak en respuesta a la invasión y anexión iraquí del Estado de Kuwait.
Esta guerra también fue llamada (por el líder iraquí Sadam Husein) como "La Madre de todas las batalla", y comúnmente conocida como Operación Tormenta del Desierto. -
El conflicto derivó en una lucha entre las tropas de la recién independizada Croacia y las fuerzas rebeldes de la minoría serbia, el bando croata apuntaba a establecer soberanía para la República de Croacia, anteriormente constituida como una república socialista dentro de la República Federal Socialista de Yugoslavia, mientras que los serbios querían quedarse en Yugoslavia, buscando nuevos límites en partes de Croacia con mayoría étnica serbia.
-
Una serie de conflictos armados a pequeña escala que estallaron entre la Guardia Republicana de Transnistria, milicianos y unidades cosacas, apoyadas por el 14º ejército ruso, la policía y ejército moldavos.
-
El conflicto internacional que se desarrolló en la actual Bosnia y Herzegovina del 6 de abril de 1992 al 14 de diciembre de 1995. Fue causada por una compleja combinación de factores políticos y religiosos: exaltación nacionalista, crisis políticas, sociales y de seguridad que siguieron al final de la guerra fría y la caída del comunismo en la antigua Yugoslavia.
-
Fue un intento de exterminio de la población tutsi por parte del gobierno hegemónico hutu de Ruanda en el que se eliminó al 75% de los tutsis.
En Ruanda, se distinguían dos estamentos dentro de la etnia banyaruanda a la que pertenece casi toda la población, la mayoría hutu y la minoría tutsi, aún cuando no existe ningún rasgo racial ni lingüístico específico que los diferencie; por lo tanto, después del genocidio ambas distinciones fueron eliminadas de los documentos de identidad. -
Un activista contra el apartheid, político y filántropo que fue elegido Presidente de Sudáfrica en el periodo de 1994 a 1999 y fue el primer mandatario de raza negra que encabezó el poder ejecutivo, y también el primero en resultar elegido por sufragio universal en su país.
-
Esta guerra comenzó cuando el Ejército ruso intentó recuperar el control de la República de Chechenia entre diciembre de 1994 y agosto de 1996, cuando tuvo lugar la devastadora y final Batalla de Grozni.
-
Fue un enfrentamiento bélico que ocurrió en el lado oriental de la Cordillera del Cóndor, sobre la cuenca del río Cenepa en territorio peruano ocupado por el ejército del Ecuador desde 1994 y que enfrentó a las fuerzas armadas del Perú y Ecuador durante los meses de enero y febrero de 1995.
-
Consistió en el rápido asalto de las tropas separatistas chechenas (en la llamada Operación Cero) sobre Grozni, capital de Chechenia.
El asalto y posterior batalla condujeron al final de la guerra, con la victoria de los rebeldes. -
Fue una guerra de nueve meses desarrollada en Zaire que tuvo el objetivo de derrocar al dictador nacionalista Mobutu.
Las fuerzas opositoras a Mobutu fueron conducidas por el líder guerrillero Laurent-Désiré Kabila con apoyo de países vecinos (en especial Ruanda y Uganda). Alcanzada Kinshasha, Kabila se declaró presidente y cambió el nombre del país a República Democrática del Congo. -
Fue el conflicto armado que tuvo lugar en gran parte del territorio de la República Democrática del Congo (el antiguo Zaire). Este conflicto terminó formalmente en 2003, cuando asumió el poder un gobierno de transición bajo los términos del Acuerdo de Pretoria. Los combatientes provenían de nueve naciones, lo que lo convierte en el conflicto continental africano más grande del que se tenga noticia y provocó la muerte de aproximadamente 3,8 millones de personas.
-
Guerra entre Yugoslavia y las fuerzas de la OTAN entre el 24 de marzo y el 10 de junio de 1999, los combatientes albaneses atacaron a las fuerzas serbias y los civiles serbios de Kosovo, mientras que las fuerzas serbias siguieron atacando a los rebeldes y civiles albaneses, produciendo una limpieza étnica que culminó con desplazamientos masivos de la población hacia países vecinos, en donde se instalaron en condiciones precarias, sin agua ni alimentos en campos de refugiados.
A list shows items. A timeline shows sequence.
Use Timetoast to make dates, milestones, and turning points easier to understand in a clear visual format. Timetoast is a timeline maker for work, school, research, and stories.